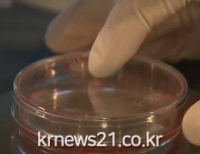
기사이미지

- 많이 본 뉴스더보기
-
-
2025-2026 절기‘인플루엔자 유행주의보’발령
[뉴스21일간=김태인 ]울산시는 질병관리청이 10월 17일 0시를 기해 ‘인플루엔자 유행주의보’를 발령함에 따라 인플루엔자 예방접종 및 호흡기감염병 예방수칙 준수를 당부하고 나섰다. 질병관리청의 인플루엔자 의사환자(ILI)* 표본감시 결과에 따르면, 2025년 40주차(9월 28일~10월 4일) 인플루엔자 의사환자 분율이** 12.1명(외래환자 1,000명...
-
카페정원‘소오소오’ 울산 제9호 민간정원으로 등록
[뉴스21일간=김태인 ]울산시는 중구 성안동에 위치한 민간정원 ‘소오소오’를 「수목원·정원의 조성 및 진흥에 관한 법률」에 따라 울산광역시 제9호 민간정원으로 등록했다고 밝혔다. ‘소오소오’는 전체 면적 1,155㎡ 가운데 470㎡(40.6%)를 녹지로 조성한 도심형 식물정원으로, 교목 9종, 관목 8종, 초화류 33종 등 총 50여 종의 식물이 ...
-
울산동구치매안심센터, 치매안심가맹점 4개소 추가 지정
동구청제공[뉴스21일간=임정훈]울산 동구치매안심센터(센터장 박수환)는 치매 환자와 가족이 안심하고 생활할 수 있는 치매 친화적 환경 조성을 위해 관내 치매 안심 가맹점 4개소를 추가 지정했다. 치매 안심 가맹점은 약국, 미용실, 카페 등 지역 주민의 생활과 밀접한 업소로, 종사자 대상 치매 파트너 교육을 통해 치매에 대한 ...
-
동구 노동자지원센터‘인구구조의 변화와 일자리의 미래’취업 특강
동구청제공[뉴스21일간=임정훈]울산 동구 노동자지원센터는 10월 23일(목) 오전 10시 ‘인구 변화와 일자리의 미래’를 주제로 중장년층 주민 대상 특강을 개최했다. 이번 강의에는 40여 명이 참석해, 급격히 변화하는 인구 구조 속에서 일자리의 방향과 개인의 역할을 함께 살펴보았다. 강의는 인구구조 변화의 의미, 저출산으로 인...
-
동구, 청소년 사회적경제·창업 체험 프로그램 운영
동구청제공[뉴스21일간=임정훈] 울산 동구는 10월 23일 오후 1시 30분부터 울산고등학교 학생 80여명과 함께 지역 사회적경제기업과 연계한 ‘청소년 사회적경제·창업 체험 프로그램’을 운영했다. 이번 프로그램은 사회적 가치를 실현하는 기업가 정신과 함께 창업의 성공과 실패 사례를 공유함으로써 청소년들이 다양한 창업...
-
울산영화인협회, 상하이 스타링크엔터테인먼트, 스타링크코리아엔터테인먼트 와 AI 숏폼 영화 협력 MOU 체결
[뉴스21일간=임정훈 ]울산영화인협회(회장 홍종오)가 중국 잔타오그룹(Zantao Group)의 문화사업 법인인 상하이 스타링크엔터테인먼트(대표 박상민), 스타링크코리아(대표 배기준)와 업무협약(MOU)을 맺고 AI 기반 숏폼 콘텐츠 제작과 숏폼영화제 개최에 나선다. 협회는 지난 17일 중국 상하이에서 스타링크엔터테인먼트와 협약식을 열...
-
남해 송정 바닷가 일몰
[뉴스21일간=김태인 ]
'우리 동네 특공대' 도용 의혹 드라마 티저 영상에 '침묵' 강요? 논란 가열 [뉴스21일간=김태인 ]최근 백동철 감독의 시나리오 '우리 동네 특공대' 도용 의혹이 불거진 하이지음스튜디오의 동명 드라마가 결국 제작되어 유튜브 등 온라인 플랫폼에 예고 티저 영상을 공개했습니다. 그러나 이 티저 영상에 대한 시청자들의 반응 중에는 도용 의혹을 제기하는 댓글들이 차단되거나 보이지 않는다는 주장이 제기되며 또...
 동구보건소, 생물테러 대비 소규모 모의훈련
동구청제공[뉴스21일간=임정훈]울산 동구보건소는 10월 31일 동구보건소 2층 보건교육실에서 경찰, 소방, 군부대 등 관련 기관과 보건소 관계자 등이 참여한 가운데 생물테러 대비·대응 소규모 모의 훈련을 했다. 이날 훈련은 ▲ 생물테러 대응 이론 교육 ▲ 개인 보호복(Level A, C) 착·탈의 ▲ 독소 다중 탐지 키트 사용법 ▲ 검체 이송 교육 ...
동구보건소, 생물테러 대비 소규모 모의훈련
동구청제공[뉴스21일간=임정훈]울산 동구보건소는 10월 31일 동구보건소 2층 보건교육실에서 경찰, 소방, 군부대 등 관련 기관과 보건소 관계자 등이 참여한 가운데 생물테러 대비·대응 소규모 모의 훈련을 했다. 이날 훈련은 ▲ 생물테러 대응 이론 교육 ▲ 개인 보호복(Level A, C) 착·탈의 ▲ 독소 다중 탐지 키트 사용법 ▲ 검체 이송 교육 ...

 [기고]동두천, 이제는 희생이 아닌 기회로 – 방위산업 클러스터가 답이다
[기고]동두천, 이제는 희생이 아닌 기회로 – 방위산업 클러스터가 답이다

시각장애 교원 특수학급 운영 역량 높인다
시각장애 교원 특수학급 운영 역량 높인다
 울산 학교운영위원장, 건강한 교육공동체 조성에 힘 모은다
울산 학교운영위원장, 건강한 교육공동체 조성에 힘 모은다
 추억 속의 섬마을 시골 학교
추억 속의 섬마을 시골 학교
 남해 양때 목장
남해 양때 목장
 제주 대록산
제주 대록산











